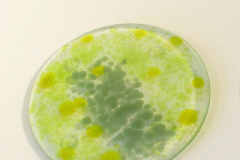
AD63_SoftGreens_sq800px72ppi
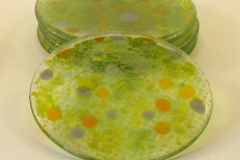
AD54_DottedYelGrn_sq600px72ppi
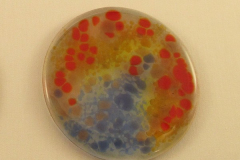
AD37_RiverRoad_sq600px72ppi

Small bowl
Great for cereal and ice cream
Pasta bowl
These shallow bowls work well for not only pasta but also for soup or stew and dessert
Serving bowl
Whether empty or filled with food, glass bowls beautify your table
Wavy bowl
Artistic and functional
Small square dish
These 6-inch square dishes can hold food and also soap, a candle, or trinkets
Short oval dish
Not too pretty to hold carrots, candy, or coins
Candle bridge
Holds 2″ ball or pillar candles
Coasters
Sets of four
Trivet
Beautifully protects the table